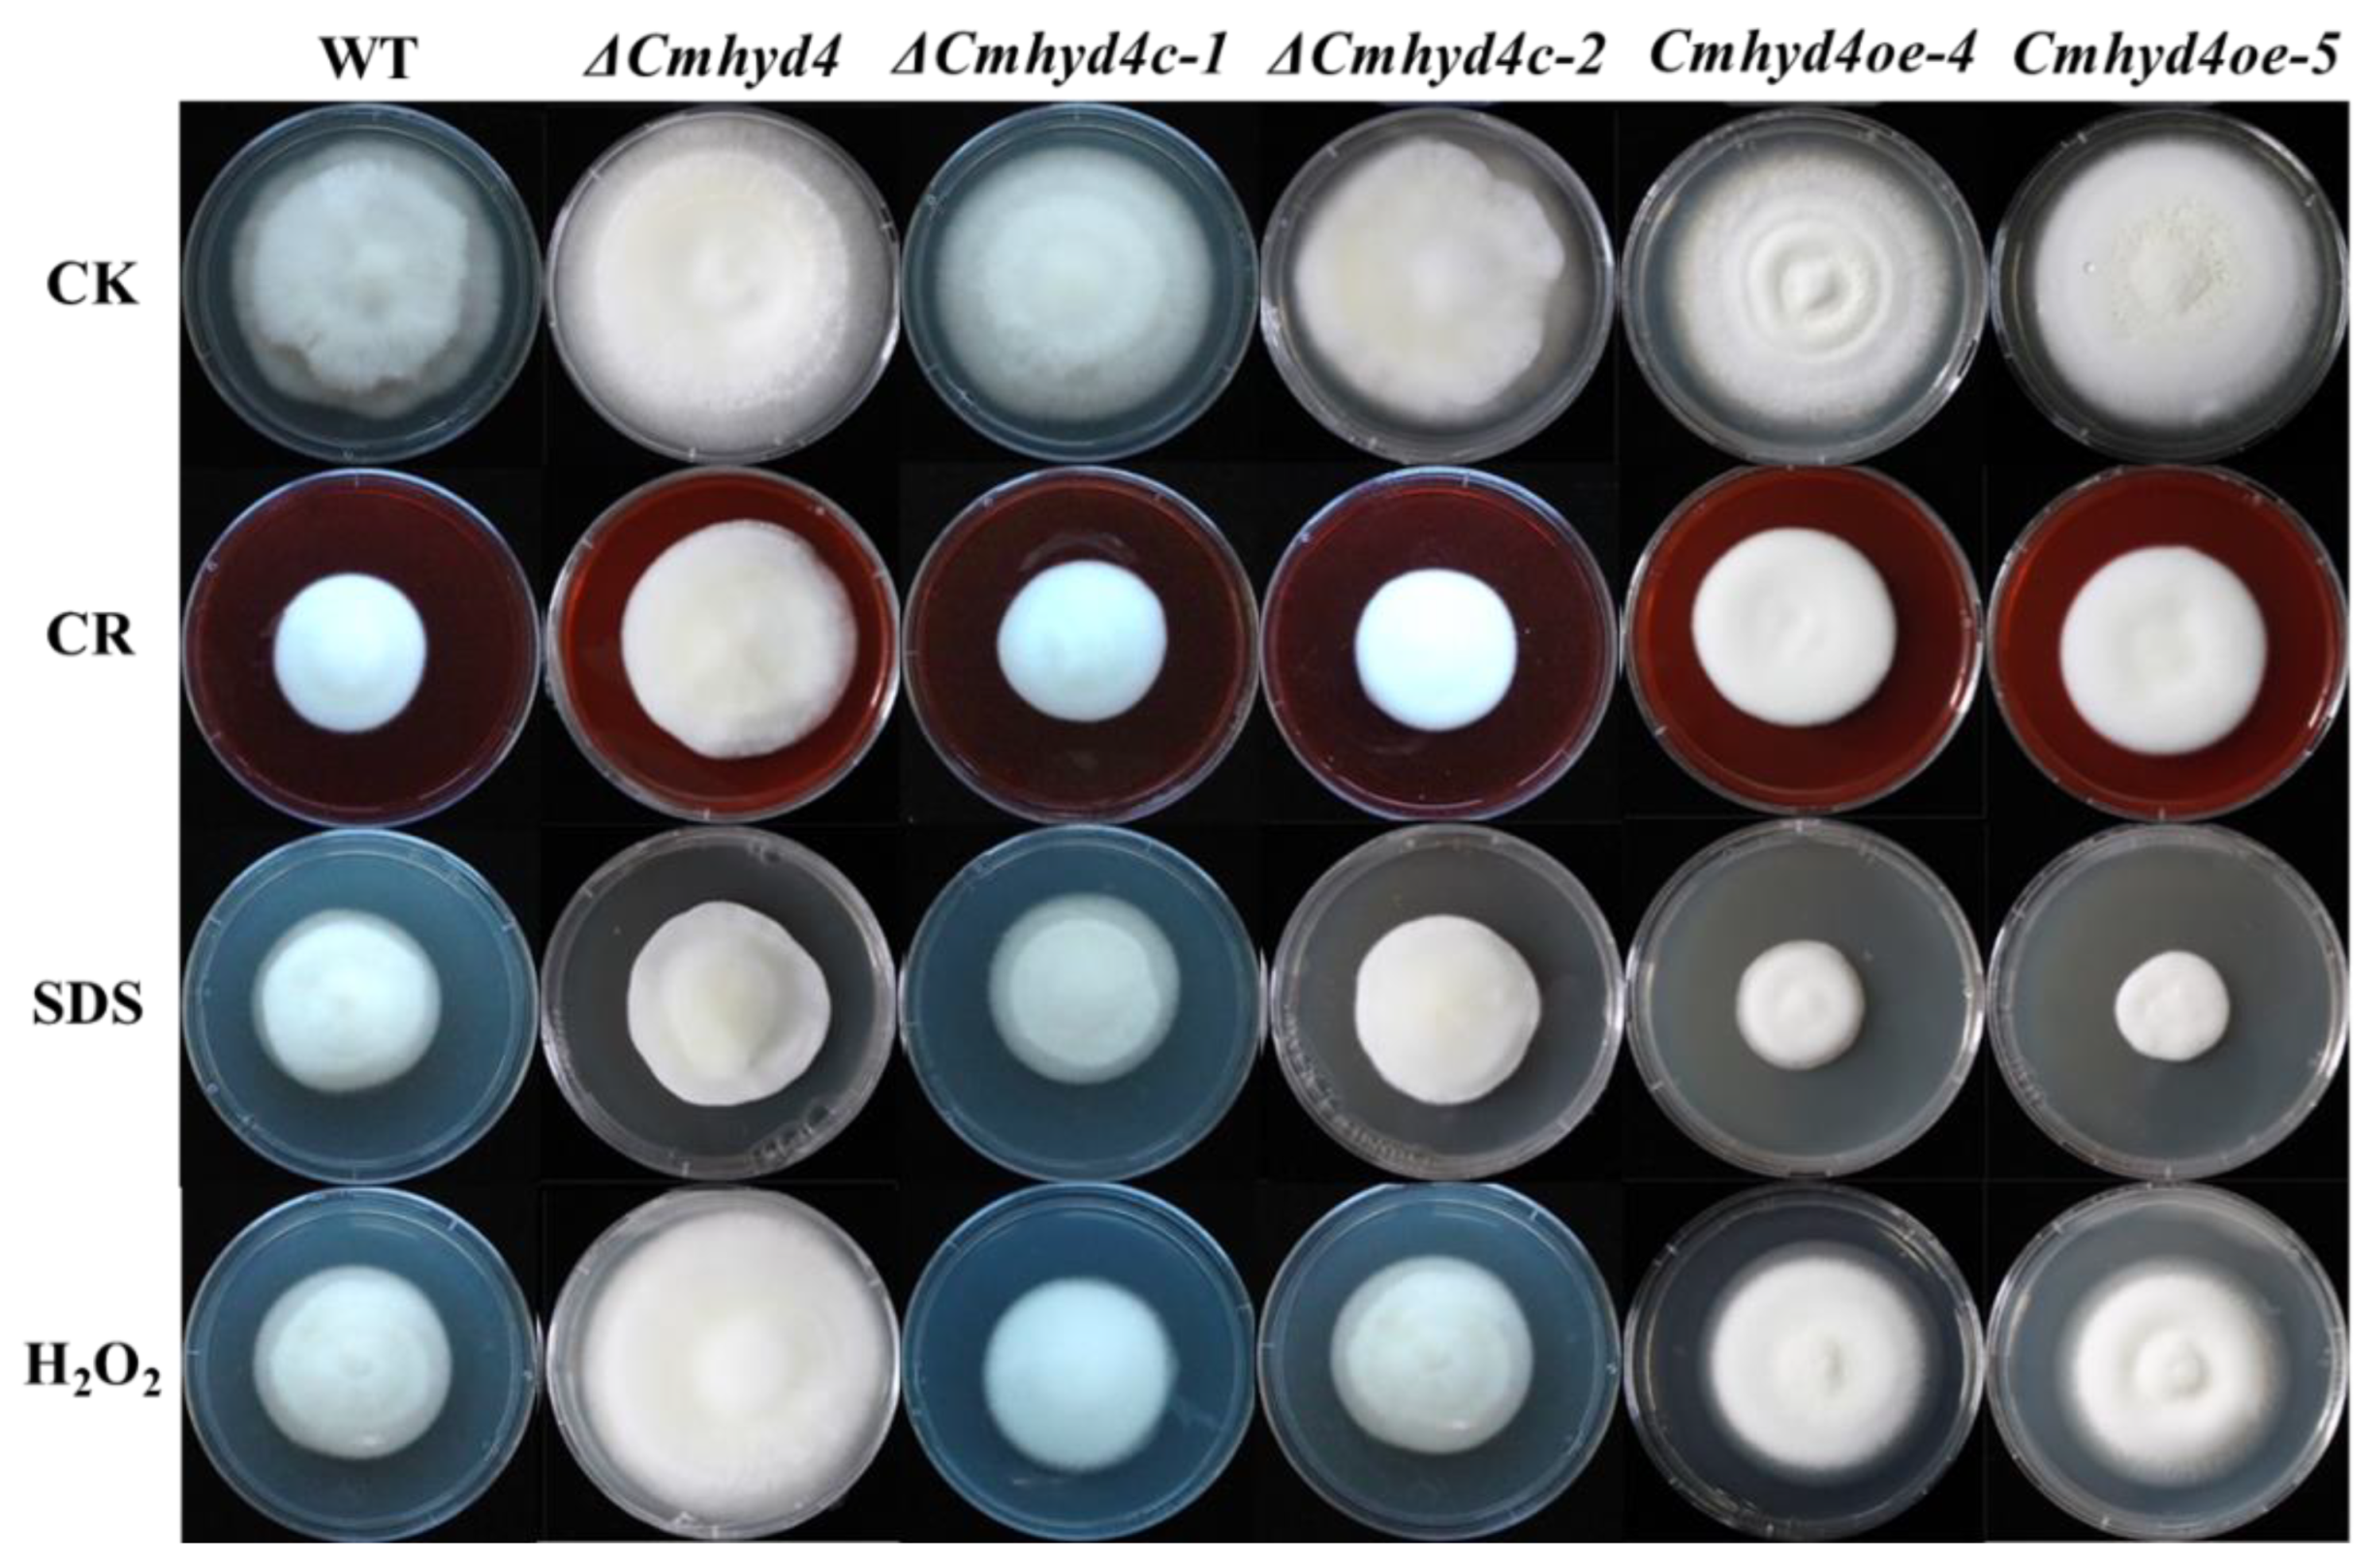
Ijms 24 04586 g005 Ijms 24 04586 g005

Hydrophobin Gene Cmhyd4 Negatively Regulates Fruiting Body Development in Edible Fungi Cordyceps militaris
Abstract
1. Introduction
2. Results
2.1. Deletion, Complementation, and Overexpression of Cmhyd4 in Cordyceps militaris
2.2. Deletion of Cmhyd4 Affects the Aerial mycelia in Darkness and the Colony Color after Light Irradiation
2.3. Deletion of Cmhyd4 Affects Carotenoid and Adenosine Production in Cordyceps militaris
2.4. Deletion of Cmhyd4 Affects Stress Responses in Cordyceps militaris
2.5. Cmhyd4 Plays no Role in Cuticle-Bypassing Infection in Pupae
2.6. Cmhyd4 Negatively Regulates Fruiting Body Development in Cordyceps militaris
3. Discussion
4. Materials and Methods
4.1. Strains and Culture Conditions
4.2. Gene Deletion, Complementation, and Overexpression
4.3. Hydrophobicity Determination for the Mycelia and Conidia
4.4. Hyphae and Conidia Observation by Scanning Electron Microscopy
4.5. Determination of Carotenoid, Cordycepin, and Adenosine Contents
4.6. Assays for Stress Adaptation
4.7. Assays for Fungal Virulence in Silkworm Pupae
4.8. Fruiting Body Formation in Cordyceps militaris
4.9. RNA Extraction and RT-qPCR Analysis
5. Conclusions
Supplementary Materials
Author Contributions
Funding
Institutional Review Board Statement
Informed Consent Statement
Data Availability Statement
Acknowledgments
Conflicts of Interest
References
- Taylor, J.W.; Berbee, M.L. Dating divergences in the Fungal Tree of Life: Review and new analyses. Mycologia 2006, 98, 838–849. [Google Scholar] [CrossRef] [PubMed]
- Elliot, M.A.; Talbot, N.J. Building filaments in the air: Aerial morphogenesis in bacteria and fungi. Curr. Opin. Microbiol. 2004, 7, 594–601. [Google Scholar] [CrossRef] [PubMed]
- Linder, M.B.; Szilvay, G.R.; Nakari-Setälä, T.; Penttilä, M.E. Hydrophobins: The protein-amphiphiles of filamentous fungi. FEMS Microbiol. Rev. 2005, 29, 877–896. [Google Scholar] [CrossRef] [PubMed]
- Wösten, H.A. Hydrophobins: Multipurpose proteins. Annu. Rev. Microbiol. 2001, 55, 625–646. [Google Scholar] [CrossRef]
- Gebbink, M.F.; Claessen, D.; Bouma, B.; Dijkhuizen, L.; Wösten, H.A. Amyloids—A functional coat for microor-ganisms. Nat. Rev. Microbiol. 2005, 3, 333–341. [Google Scholar] [CrossRef]
- Dubey, M.K.; Jensen, D.F.; Karlsson, M. Hydrophobins are required for conidial hydrophobicity and plant root colonization in the fungal biocontrol agent Clonostachys rosea. BMC Microbiol. 2014, 14, 18. [Google Scholar] [CrossRef]
- Tao, Y.X.; Chen, R.L.; Yan, J.J.; Long, Y.; Tong, Z.J.; Song, H.B.; Xie, B.G. A hydrophobin gene, Hyd9, plays an important role in the formation of aerial hyphae and primordia in Flammulina filiformis. Gene 2019, 706, 84–90. [Google Scholar] [CrossRef]
- Xu, D.; Wang, Y.; Keerio, A.A.; Ma, A. Identification of hydrophobin genes and their physiological functions related to growth and development in Pleurotus ostreatus. Microbiol. Res. 2021, 247, 126723. [Google Scholar] [CrossRef]
- Banerjee, G.; Robertson, D.L.; Leonard, T.J. Hydrophobins Sc3 and Sc4 gene expression in mounds, fruiting bodies and vegetative hyphae of Schizophyllum commune. Fungal. Genet. Biol. 2008, 45, 171–179. [Google Scholar] [CrossRef]
- Aimanianda, V.; Bayry, J.; Bozza, S.; Kniemeyer, O.; Perruccio, K.; Elluru, S.R.; Clavaud, C.; Paris, S.; Brakhage, A.A.; Kaveri, S.V.; et al. Surface hydrophobin prevents immune recognition of airborne fungal spores. Nature 2009, 460, 1117–1121. [Google Scholar] [CrossRef]
- Plett, J.M.; Gibon, J.; Kohler, A.; Duffy, K.; Hoegger, P.J.; Velagapudi, R.; Han, J.; Kües, U.; Grigoriev, I.V.; Martin, F. Phylogenetic, genomic organization and expression analysis of hydrophobin genes in the ectomycorrhizal basidiomycete Laccaria bicolor. Fungal. Genet. Biol. 2012, 49, 199–209. [Google Scholar] [CrossRef] [PubMed]
- Vila, T.; Nazir, R.; Rozental, S.; Dos Santos, G.M.; Calixto, R.O.; Barreto-Bergter, E.; Wick, L.Y.; van Elsas, J.D. The Role of hydrophobicity and surface receptors at hyphae of Lyophyllum sp. strain karsten in the interaction with Burkholderia terrae BS001-implications for interactions in soil. Front. Microbiol. 2016, 7, 1689. [Google Scholar] [CrossRef] [PubMed]
- Luciano-Rosario, D.; Eagan, J.L.; Aryal, N.; Dominguez, E.G.; Hull, C.M.; Keller, N.P. The Hydrophobin gene family confers a fitness trade-off between spore dispersal and host colonization in Penicillium expansum. mBio 2022, 13, e0275422. [Google Scholar] [CrossRef] [PubMed]
- Askolin, S.; Penttila, M.; Wosten, H.A.; Nakari-Setala, T. The Trichoderma reesei hydrophobin genes hfb1 and hfb2 have diverse functions in fungal development. FEMS Microbiol. Lett. 2005, 253, 281–288. [Google Scholar] [CrossRef] [PubMed]
- Grünbacher, A.; Throm, T.; Seidel, C.; Gutt, B.; Röhrig, J.; Strunk, T.; Vincze, P.; Walheim, S.; Schimmel, T.; Wenzel, W.; et al. Six hydrophobins are involved in hydrophobin rodlet formation in Aspergillus nidulans and contribute to hydrophobicity of the spore surface. PLoS ONE 2014, 9, e94546. [Google Scholar] [CrossRef]
- Cai, F.; Zhao, Z.; Gao, R.; Chen, P.; Ding, M.; Jiang, S.; Fu, Z.; Xu, P.; Chenthamara, K.; Shen, Q.; et al. The pleiotropic functions of intracellular hydrophobins in aerial hyphae and fungal spores. PLoS Genet. 2021, 17, e1009924. [Google Scholar] [CrossRef]
- Zhang, S.; Xia, Y.X.; Kim, B.; Keyhani, N.O. Two hydrophobins are involved in fungal spore coat rodlet layer assembly and each play distinct roles in surface interactions, development and pathogenesis in the entomopathogenic fungus, Beauveria bassiana. Mol. Microbiol. 2011, 80, 811–826. [Google Scholar] [CrossRef]
- Li, X.; Wang, F.; Liu, M.Q.; Dong, C.H. Hydrophobin CmHYD1 is involved in conidiation, infection and primordium formation, and regulated by nitrogen regulatory transcription factor CmAreA in edible fungus, Cordyceps militaris. J. Fungi. 2021, 7, 674. [Google Scholar] [CrossRef]
- Li, X.; Wang, F.; Xu, Y.Y.; Dong, C.H. Cysteine-rich hydrophobin gene family: Genome wide analysis, phylogeny and putative function in Cordyceps militaris. Int. J. Mol. Sci. 2020, 22, 643. [Google Scholar] [CrossRef]
- Shrestha, B.; Zhang, W.; Zhang, Y.; Liu, X. The medicinal fungus Cordyceps militaris: Research and development. Mycol. Prog. 2012, 11, 599–614. [Google Scholar] [CrossRef]
- Guo, M.M.; Guo, S.P.; Yan, H.J.; Bu, N.; Dong, C.H. Comparison of major bioactive compounds of the caterpillar medicinal mushroom, Cordyceps militaris (Ascomycetes), fruiting bodies cultured on wheat substrate and pupae. Int. J. Med. Mushrooms 2016, 18, 327–336. [Google Scholar] [CrossRef]
- Xia, Y.; Luo, F.; Shang, Y.; Chen, P.; Lu, Y.; Wang, C. Fungal cordycepin biosynthesis is coupled with the production of the safeguard molecule pentostatin. Cell Chem. Biol. 2017, 24, 1479–1489.e4. [Google Scholar] [CrossRef]
- Dong, J.Z.; Wang, S.H.; Ai, X.R.; Yao, L.; Sun, Z.W.; Lei, C.; Wang, Y.; Wang, Q. Composition and characterization of cordyxanthins from Cordyceps militaris fruit bodies. J. Funct. Foods. 2013, 5, 1450–1455. [Google Scholar] [CrossRef]
- Yang, T.; Guo, M.M.; Yang, H.; Guo, S.; Dong, C.H. The blue-light receptor CmWC-1 mediates fruit body development and secondary metabolism in Cordyceps militaris. Appl. Microbiol. Biotechnol. 2016, 100, 743–755. [Google Scholar] [CrossRef]
- Zhang, J.J.; Wang, F.; Yang, Y.; Wang, Y.; Dong, C.H. CmVVD is involved in fruiting body development and carotenoid production and the transcriptional linkage among three blue-light receptors in edible fungus Cordyceps militaris. Environ. Microbiol. 2020, 22, 466–482. [Google Scholar] [CrossRef]
- Yang, Y.; Bu, N.; Wang, S.; Zhang, J.; Wang, Y.; Dong, C.H. Carotenoid production by caterpillar medicinal mushrooms, Cordyceps militaris (Ascomycetes), under different culture conditions. Int. J. Med. Mushrooms 2020, 22, 1191–1201. [Google Scholar] [CrossRef]
- Jin, Y.; Meng, X.; Qiu, Z.; Su, Y.; Yu, P.; Qu, P. Anti-tumor and anti-metastatic roles of cordycepin, one bioactive compound of Cordyceps militaris. Saudi. J. Biol. Sci. 2018, 25, 991–995. [Google Scholar] [CrossRef]
- Dong, J.Z.; Liu, M.R.; Lei, C.; Zheng, X.J.; Wang, Y. Effects of selenium and light wavelengths on liquid culture of Cordyceps militaris Link. Appl. Biochem. Biotech. 2012, 166, 2030–2036. [Google Scholar] [CrossRef] [PubMed]
- Zheng, P.; Xia, Y.L.; Xiao, G.H.; Xiong, C.H.; Hu, X.; Zhang, S.W.; Zheng, H.J.; Huang, Y.; Zhou, Y.; Wang, S.Y.; et al. Genome sequence of the insect pathogenic fungus Cordyceps militaris, a valued traditional Chinese medicine. Genome Biol. 2011, 12, R116. [Google Scholar] [CrossRef] [PubMed]
- Xiao, G.H.; Ying, S.H.; Zheng, P.; Wang, Z.L.; Zhang, S.W.; Xie, X.Q.; Shang, Y.F.; St Leger, R.J.; Zhao, G.P.; Wang, C.S.; et al. Genomic perspectives on the evolution of fungal entomopathogenicity in Beauveria bassiana. Sci. Rep. 2012, 2, 483. [Google Scholar] [CrossRef] [PubMed]
- Paris, S.; Debeaupuis, J.P.; Crameri, R.; Carey, M.; Charlès, F.; Prévost, M.C.; Schmitt, C.; Philippe, B.; Latgé, J.P. Conidial hydrophobins of Aspergillus fumigatus. Appl. Environ. Microb. 2003, 69, 1581–1588. [Google Scholar] [CrossRef] [PubMed]
- Kim, S.; Ahn, I.P.; Rho, H.S.; Lee, Y.H. MHP1, a Magnaporthe grisea hydrophobin gene, is required for fungal development and plant colonization. Mol. Microbiol. 2005, 57, 1224–1237. [Google Scholar] [CrossRef] [PubMed]
- Wu, T.; Zhang, Z.; Hu, C.; Zhang, L.; Wei, S.; Li, S. A WD40 protein encoding gene Fvcpc2 positively regulates mushroom development and yield in Flammulina velutipes. Front. Microbiol. 2020, 11, 498. [Google Scholar] [CrossRef] [PubMed]
- Wu, T.; Hu, C.; Xie, B.; Zhang, L.; Yan, S.; Wang, W.; Tao, Y.; Li, S. A single transcription factor (PDD1) determines development and yield of winter mushroom (Flammulina velutipes). Appl. Environ. Microb. 2019, 85, e01735-19. [Google Scholar] [CrossRef] [PubMed]
- Zhang, G.; Ren, A.; Shi, L.; Zhu, J.; Jiang, A.; Shi, D.; Zhao, M. Functional analysis of an APSES transcription factor (GlSwi6) involved in fungal growth, fruiting body development and ganoderic-acid biosynthesis in Ganoderma lucidum. Microbiol. Res. 2018, 207, 280–288. [Google Scholar] [CrossRef]
- Ohm, R.A.; de Jong, J.F.; Lugones, L.G.; Aerts, A.; Kothe, E.; Stajich, J.E.; de Vries, R.P.; Record, E.; Levasseur, A.; Baker, S.E.; et al. Genome sequence of the model mushroom Schizophyllum commune. Nat. Biotechnol. 2010, 28, 957–963. [Google Scholar] [CrossRef]
- Ohm, R.A.; de Jong, J.F.; de Bekker, C.; Wösten, H.A.; Lugones, L.G. Transcription factor genes of Schizophyllum commune involved in regulation of mushroom formation. Mol. Microbiol. 2011, 81, 1433–1445. [Google Scholar] [CrossRef]
- Pelkmans, J.F.; Patil, M.B.; Gehrmann, T.; Reinders, M.J.; Wösten, H.A.; Lugones, L.G. Transcription factors of Schizophyllum commune involved in mushroom formation and modulation of vegetative growth. Sci. Rep. 2017, 7, 310. [Google Scholar] [CrossRef]
- Wu, T.; Hu, C.; Xie, B.; Wei, S.; Zhang, L.; Zhu, Z.; Zhang, Z.; Li, S. A putative transcription factor LFC1 negatively regulates development and yield of winter mushroom. Appl. Microbiol. Biot. 2020, 104, 5827–5844. [Google Scholar] [CrossRef]
- Lau, G.; Hamer, J.E. Regulatory genes controlling MPG1 expression and pathogenicity in the rice blast fungus Magnaporthe grisea. Plant Cell. 1996, 8, 771–781. [Google Scholar] [CrossRef]
- Soanes, D.M.; Kershaw, M.J.; Cooley, R.N.; Talbot, N.J. Regulation of the MPG1 hydrophobin gene in the rice blast fungus Magnaporthe grisea. Mol. Plant-Microbe. Interact. 2002, 15, 1253–1267. [Google Scholar] [CrossRef] [PubMed]
- Fang, W.G.; Pei, Y.; Bidochka, M.J. A regulator of a G protein signalling (RGS) gene, cag8, from the insect-pathogenic fungus Metarhizium anisopliae is involved in conidiation, virulence and hydrophobin synthesis. Microbiology 2007, 153, 1017–1025. [Google Scholar] [CrossRef] [PubMed]
- Ries, L.N.; Beattie, S.R.; Espeso, E.A.; Cramer, R.A.; Goldman, G.H. Diverse regulation of the CreA carbon catabolite repressor in Aspergillus nidulans. Genetics 2016, 203, 335–352. [Google Scholar] [CrossRef] [PubMed]
- Lai, Y.L.; Cao, X.; Chen, J.J.; Wang, L.L.; Wei, G.; Wang, S.B. Coordinated regulation of infection-related morphogenesis by the KMT2-Cre1-Hyd4 regulatory pathway to facilitate fungal infection. Sci. Adv. 2020, 6, eaaz1659. [Google Scholar] [CrossRef] [PubMed]
- Li, Y.; Sun, T.; Guo, D.; Gao, J.; Zhang, J.; Cai, F.; Fischer, R.; Shen, Q.; Yu, Z. Comprehensive analysis of the regulatory network of blue-light-regulated conidiation and hydrophobin production in Trichoderma guizhouense. Environ. Microbiol. 2021, 23, 6241–6256. [Google Scholar] [CrossRef] [PubMed]
- Zhang, J.J.; Wang, F.; Liu, M.Q.; Fu, M.; Dong, C.H. Dynamic genome-wide transcription profiling and direct target genes of CmWC-1 reveal hierarchical light signal transduction in Cordyceps militaris. J. Fungi. 2022, 8, 624. [Google Scholar] [CrossRef] [PubMed]
- Meng, G.L.; Wang, X.; Liu, M.Q.; Wang, F.; Liu, Q.; Dong, C.H. Efficient CRISPR/Cas9 system based on autonomously replicating plasmid with an AMA1 sequence and precisely targeted gene deletion in the edible fungus, Cordyceps militaris. Microbial. Biotechnol. 2022, 15, 2594–2606. [Google Scholar] [CrossRef]
- Yang, T.; Dong, C.H. Photo morphogenesis and photo response of the blue-light receptor gene Cmwc-1 in different strains of Cordyceps militaris. FEMS Microbiol. Lett. 2014, 352, 190–197. [Google Scholar] [CrossRef]
- Dong, C.H.; Yao, Y.J. Comparison of some metabolites among cultured mycelia of Ophiocordyceps sinensis from different geographical regions. Int. J. Med. Mushrooms 2010, 12, 287–297. [Google Scholar] [CrossRef]
- Lian, T.T.; Yang, T.; Liu, G.J.; Sun, J.D.; Dong, C.H. Reliable reference gene selection for Cordyceps militaris gene expression studies under different developmental stages and media. FEMS Microbiol. Lett. 2014, 356, 97–104. [Google Scholar] [CrossRef]
- Livak, K.J.; Schmittgen, T.D. Analysis of relative gene expression data using real-time quantitative PCR and the 2−ΔΔCT method. Methods 2001, 25, 402–408. [Google Scholar] [CrossRef] [PubMed]

Disclaimer/Publisher’s Note: The statements, opinions and data contained in all publications are solely those of the individual author(s) and contributor(s) and not of MDPI and/or the editor(s). MDPI and/or the editor(s) disclaim responsibility for any injury to people or property resulting from any ideas, methods, instructions or products referred to in the content. |
© 2023 by the authors. Licensee MDPI, Basel, Switzerland. This article is an open access article distributed under the terms and conditions of the Creative Commons Attribution (CC BY) license (https://creativecommons.org/licenses/by/4.0/).
Share and Cite
Li, X.; Liu, M.; Dong, C. Hydrophobin Gene Cmhyd4 Negatively Regulates Fruiting Body Development in Edible Fungi Cordyceps militaris. Int. J. Mol. Sci. 2023, 24, 4586. https://doi.org/10.3390/ijms24054586
Li X, Liu M, Dong C. Hydrophobin Gene Cmhyd4 Negatively Regulates Fruiting Body Development in Edible Fungi Cordyceps militaris. International Journal of Molecular Sciences. 2023; 24(5):4586. https://doi.org/10.3390/ijms24054586
Chicago/Turabian StyleLi, Xiao, Mengqian Liu, and Caihong Dong. 2023. "Hydrophobin Gene Cmhyd4 Negatively Regulates Fruiting Body Development in Edible Fungi Cordyceps militaris" International Journal of Molecular Sciences 24, no. 5: 4586. https://doi.org/10.3390/ijms24054586
APA StyleLi, X., Liu, M., & Dong, C. (2023). Hydrophobin Gene Cmhyd4 Negatively Regulates Fruiting Body Development in Edible Fungi Cordyceps militaris. International Journal of Molecular Sciences, 24(5), 4586. https://doi.org/10.3390/ijms24054586

